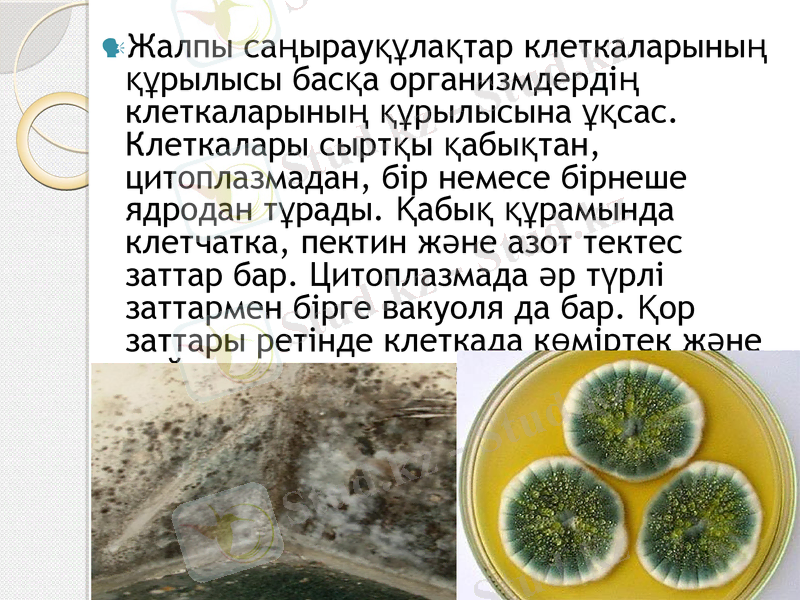
Slide 5

Саңырауқұлақтардың морфологиясы мен физиологиясы: құрылымы, жіктелуі және медицинадағы қолданылуы



Презентация
Тақырыбы:Саңырауқұлақтардың морфологиясы және физиологиясы
Орындаған: Аймахан Н. Ә.
Қабылдаған:
ОҢТҮСТІК ҚАЗАҚСТАН МЕДИЦИНА АКАДЕМИЯСЫ

Жоспар
І. Кіріспе
ІІ. Негізгі бөлім
Саңырауқұлақтар
Саңырауқұлақтардың құрылысы
Саңырауқұлақтардың класы
Медицинада қолданылуы
ІІІ. Қорытынды
1. Саңырауқұлақтар туғызатын аурулар.
ІV. Пайдаланылған әдебиеттер

Саңырауқұлақтар эукариотты микроорганизмдердің әртекті топтары. Саңырауқұлақтар ядролық қабықшасы бар ядродан, органеллалары бар цитоплазмадан, цитоплазмалық мембранадан(құрамында фосфолипидтер мен стеролдары бар) және глюкан, целлюлоза, хитин, ақуыз, липидтер т. б. бар күрделі жасуша қабырғансынан тұрады. Саңырауқұлақтар мицелиде шумақталатын ұзын жіңішке жіпшелерден тұрады. Төмен деңгейдегі саңырауқұлақтар гифтерінің - фикомицеттердің - аралық қалқалары жоқ. Жоғары деңгейдегі саңырауқұлақтарды - эумицеттерде - гифтері аралық қалқалармен бөлінеді; олардың мицелилері көп жасушалы.

Саңырауқұлақтардың құрылысы. Саңырауқұлақтардың денесі өте нәзік жіпшелерден, яғни гифтерден тұрады. Бұл гифтердің өз ара шатасып орналасуынан барып мицелий пайда болады. Кейбір саңырауқұлақтардың денесі жіптерден құралмайды. Мұндай саңырауқұлақтардың басым көпшілігі өсімдіктер ауруын қоздырады. Мәселен, бұларға картоптың рак ауруын қоздыратын сақырауқұлақтар жатады. Саңырауқұлақтар бір клеткалы және көп клеткалы болып бөлінеді. Бір клеткалы саңырауқұлақтың бұтақталған мицелийі бір ғана клеткадан тұрады, ал көп клеткалы саңырауқұлақтардың гифінде аралық перделер болады.
Жалпы саңырауқұлақтар клеткаларының құрылысы басқа организмдердің клеткаларының құрылысына ұқсас. Клеткалары сыртқы қабықтан, цитоплазмадан, бір немесе бірнеше ядродан тұрады. Қабық құрамында клетчатка, пектин және азот тектес заттар бар. Цитоплазмада әр түрлі заттармен бірге вакуоля да бар. Қор заттары ретінде клеткада көміртек және май заттары кездеседі.

Саңырауқұлақтар спораларымен жынысты және жыныссыз жолдармен сондай-ақ вегетативті жолмен көбейеді (бүршіктену немесе гифтің бөлшектенуі) . Жынысты және жыныссыз жорлмен көбейетін саңырауқұлақтарды жетілген деп атайды. Ал, жынысты көбею жолы жоқ немесе әлі де анықталмаған саңырауқұлақтарды жетілмеген деп атайды. Саңырауқұлақтарда жыныссыз көбею домалақ құрылымның - спорангияның ішінде жетілетін эндогенді споралардың және ұрық тасымалдаушы гифтердің ұшында түзілетін конидийлердің - экзогенді споралардың көмегімен жүзеге асады.

Кейбір саңырауқұлақтардың осындай гифтерінің ұшында споралар бірден, топталып немесе моншақталып орналасады. Бұл спораларды конидий, ал олар орналасқан гифтені диеносцалар деп атайды. Пісіп жетілген кезде конидий шашылады да, қолайлы жағдай туғанда көбейеді.
Басқа саңырауқұлақтарда споралар спорангиеносцалар деп аталатын гифтердің үшындағы дөңгелекспорангийлер ішінде түзіледі. Пісіп жетілген спорангийлер жарылып, споралары төгіледі. Бұлар да қолайлы жағдайға тап болса көбейіп, жаңадан саңыраукұлақ біреді. Саңырауқұлақ споралары орасан көп және олар едәуір қашықтыққа дейін таралады. Конидийлер де, спорангийлер де пішіні және бояуы жағынан түрліше болып келеді. Міне бұл қаеиеттер оларды анықтау үшін қолданылады.

Саңырауқұлақтарды 7 класқа бөлуге болады: хитридомицеттер, гифохитридомицеттер, оомицеттер, зигомицеттер, аскомицеттер, базидиомицеттер, дейтеромицеттер.

Фикомицеттерді келесі топқа бөледі: Хитридомицеттер немесе су саңырауқұлақтары, бұлап сапрофитті өмір сүреді. Немесе балдырларды зақымдайды. ; гифохитридомицеттер-хитридомицеттер мен оомицеттерге ұқсас; оомицеттер - өсімдіктердің және су көгерткіштерінің паразиттері; зигомицеттер - Mucor туыстығы өкілдерін құрайды, бұлар топырақ пен ауада кең тараған және өкпенің, бас миының және басқа мүшелердің мукоромикоз ауруын туғызуға қабілетті.

Жыныссыз көбеюде ұрықтық спорангия түзеді, бұл көптеген споралардан тұратын қабықшасы қалың құрылым. Зигомицеттердегі жынысты көбею зигоспораның немесе ооспораның түзілуі жолымен қамтамасыз етіледі.
Спорангий
Спорангийлерді тасымалдаушы
Конидиялар
Стеригмалар
Конидияларды тасымалдаушы

Эумицеттер - аскомицеттерден, базидомицеттерден (жетілген саңырауқұлақтар), дейтеромицеттерден (жетілмеген) тұрады. Аскомицеттер (немесе қалтылы саңырауқұлақтар) секпталанған мицелилерден тұратын және жынысты көбеюге қабілетімен ерекшеленетін саңырауқұлақтар топтарын біріктіреді. Аскомицеттердің аты 4 немес 8 гаплоидты жыныстық споралардан (аскоспора) тұратын қалтадан немесе аскпен байланысты.

Аскомицеттерге Aspergillus, Penicillium туыстық өкілдері жатады, олар бір-бірінен ұрық тасымалдаушы гифтері арқылы ерекшеленеді. Aspergillus - те (су сепкіш тәрізді көгерткіш) ұрықтық конидия тасымалдаушы гифтерінің ұшында жуандылық байқалады, оны стеригма деп атайды, онда спора тізбектері - конидиялар түзіледі. Аспергилдердің кейбір түрлері аспергиллез және афлатоксикозды тудыруы мүмкін.

Penicillium туыстығы саңырауқұлақтардың ұрық тасымалдаушы гифтері шашаққа ұқсас, оның ұшында ұсақ құрылымдарға тармақталатын стиригмалар бар, олардың үстінде конидия тізбегі орналасқан, бұлар пеницеллиноз ауруын тудыруы мүмкін. Аскомицеттердің көптеген түрлері антибиотиктердің өнімдері болып табылады.

Аскомицеттер өкілділігіне біржасушалы саңырауқұлақтар - ашытқыларда жатады, олар шынайы мицелиді түзу қабілетінен айырылған. Ашытқылар жасушасы сопақша пішінді. Олар бүршіктену, бинарлы бөліну (екі бірдей жасушаның пайда болуы) немесе аскоспор түзе отырып жынысты жолмен көбейеді. Ашытқыларды биотехнологиялық процесстер кезінде қолданады.

Ашытқылардың кейбір түрлері туғызатын аурулар ашытқылар микоздар деп аталады. Аскомицеттерге эрготизм қоздырғышы немесе дәндерде паразитті өмір сүретін қара күйелер жатады.
Базидиомицеттер - септаланған мицелилері бар қалпақты саңырауқұлақтар.
Дитеромицеттер - жетілмеген саңырауқұлақтар шартты саңырауқұлақтар класына жатады, жынысты көбеюі жоқ септаланған мицелилері бар саңырауқұлақтарды біріктіреді. Олар тек жыныссыз жолмен көбейіп конидия түзеді.


Саңырауқұлақтардың құрамы ферменттерге бай. Ферменттерді әр түрлі салаға пайдаланады, олар: жеміс шырынының түсін өзгертеді; шикізаттарды (мал азығын, қағаз қалдықтарын) өңдейді; нәруыздарды, крахмалды сүйылтады.
Зең саңырауқұлағынан пенициллин антибиотигі алынады. Аспергилден лимон қышқылы өндіріліп, медицинада, өнеркәсіпnе кеңінен қолданылады.
Жеуге жарамды қалпақшалы саңырауқұлақтар мен ашытқы саңырауқұлақтары тағамға пайдаланылады.
Тутанхомон фараонының қорымын ашуға қатысқан 21 адам аспергилл саңырауқұлағының споралары өкпені зақымдағандықтан, өмірден озды. Оны кейін басқа египет қорымдарындағы адам мүдделеріне қаптал өскен аспергилдер арқылы анықтаған.

- Іс жүргізу
- Автоматтандыру, Техника
- Алғашқы әскери дайындық
- Астрономия
- Ауыл шаруашылығы
- Банк ісі
- Бизнесті бағалау
- Биология
- Бухгалтерлік іс
- Валеология
- Ветеринария
- География
- Геология, Геофизика, Геодезия
- Дін
- Ет, сүт, шарап өнімдері
- Жалпы тарих
- Жер кадастрі, Жылжымайтын мүлік
- Журналистика
- Информатика
- Кеден ісі
- Маркетинг
- Математика, Геометрия
- Медицина
- Мемлекеттік басқару
- Менеджмент
- Мұнай, Газ
- Мұрағат ісі
- Мәдениеттану
- ОБЖ (Основы безопасности жизнедеятельности)
- Педагогика
- Полиграфия
- Психология
- Салық
- Саясаттану
- Сақтандыру
- Сертификаттау, стандарттау
- Социология, Демография
- Спорт
- Статистика
- Тілтану, Филология
- Тарихи тұлғалар
- Тау-кен ісі
- Транспорт
- Туризм
- Физика
- Философия
- Халықаралық қатынастар
- Химия
- Экология, Қоршаған ортаны қорғау
- Экономика
- Экономикалық география
- Электротехника
- Қазақстан тарихы
- Қаржы
- Құрылыс
- Құқық, Криминалистика
- Әдебиет
- Өнер, музыка
- Өнеркәсіп, Өндіріс
Қазақ тілінде жазылған рефераттар, курстық жұмыстар, дипломдық жұмыстар бойынша біздің қор #1 болып табылады.



Ақпарат
Қосымша
Email: info@stud.kz